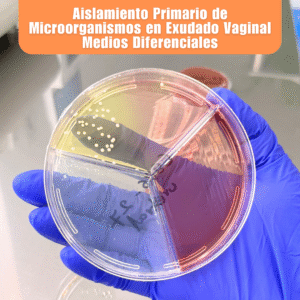
Laboratorio de Microbiología 3 Laboratorio de Microbiologia Aislamiento Primario de Microorganismos en Exudado Vaginal Medios Diferenciales

Laboratorio de Microbiología
El Laboratorio de Microbiología se especializa en la detección e identificación de microorganismos como bacterias, hongos y otros agentes que pueden causar infecciones en el organismo. A través de diferentes estudios microbiológicos es posible determinar la presencia del microorganismo responsable de una infección y, en muchos casos, identificar cuáles son los antibióticos más adecuados para su tratamiento, lo que permite a los médicos indicar terapias más efectivas y seguras.
El Departamento de Microbiología Médica se constituye como una unidad estratégica de alta especialización, donde contamos con procesos de análisis confiables, equipo especializado y personal capacitado, enfocados en proporcionar resultados precisos que apoyen el diagnóstico médico oportuno. Nuestra misión fundamental es proveer evidencia científica de precisión para sustentar la toma de decisiones clínicas, garantizando la seguridad del paciente a través de la excelencia analítica.
Consulte a su médico ya que es el único facultado para indicar el tipo de estudio a realizar en cada paciente de acuerdo a su historia clínica e interpretar los resultados.
Lista de Estudios de Laboratorio de Microbiología
- Baciloscopias
- Urocultivo con Antibiograma/MIC
- Coprocultivo con Antibiograma/MIC
- Hemocultivo Aerobio y Anaerobio/MIC
- Cultivo de heridas Aerobio y Anaerobio/MIC
- Cultivo de secreciones Aerobio y Anaerobio/MIC
- Cultivo de exudado Faríngeo con Antibiograma/MIC
- Cultivo de semen con Micoplasma y Ureaplasma/MIC
- Cultivo de exudado Uretral con Micoplasma y Ureaplasma/MIC
- Cultivo de exudado Vaginal con Micoplasma y Ureaplasma/MIC
- Cultivos micológicos